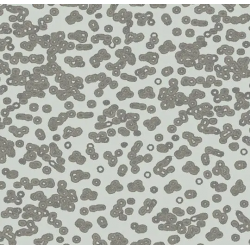
Bacteria 990201
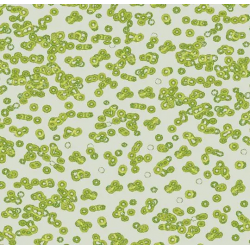
Bacteria 990203

: Forbo
Colectia Flotex a celor de la Forbo reprezinta ultima inovatie in domeniul pardoselilor, oferind proprietati similare cu ale PVC-ului si confort asemanator mochetelor. Avand un strat de baza din PVC, si peste 80 milioane de fibre de poliamida la suprafata, aceasta mocheta este speciala prin insasi compozitia sa: stratul de baza ii ofera stabilitate dimensionala, si o face antibacteriana, antiderapanta, usor de montat, iar textura firelor de poliamida ii confera rezistenta la trafic intens, dar si un plus de confort la atingere.
Cu o gama mare de culori (peste 50 in fiecare colectie), si cu posibilitatea de a fi produsa atat in role, cat si in dale si plank-uri, mocheta Flotex este alegerea arhitecturala perfecta pentru orice spatiu cu pretentii.
Colectia Sottsass este dezvoltata in colaborare cu prestigiosul studio de design Sottsass Associati din Italia.
Colectia Sottsass cuprinde 3 designuri: Bacteria, Terrazzo si Wool.

Cum comanzi? Simplu contacteaza-ne utilizand datele de mai jos.

0744.888.000

office@glamourfloors.ro
 Bacteria design
Bacteria design
 Bacteria 990101
Bacteria 990101
 Bacteria 990102
Bacteria 990102
 Bacteria 990103
Bacteria 990103
 Bacteria 990104
Bacteria 990104
 Bacteria 990105
Bacteria 990105
 Bacteria 990106
Bacteria 990106
Bacteria 990201
Bacteria 990201
 Bacteria 990202
Bacteria 990202
Bacteria 990203
Bacteria 990203
 Bacteria 990301
Bacteria 990301
 Bacteria 990302
Bacteria 990302
 Bacteria 990303
Bacteria 990303
 Bacteria 990304
Bacteria 990304
 Bacteria 990401
Bacteria 990401
 Bacteria 990402
Bacteria 990402
 Bacteria 990403
Bacteria 990403
 Bacteria 990404
Bacteria 990404
 Bacteria 990501
Bacteria 990501
 Bacteria 990502
Bacteria 990502
 Bacteria 990503
Bacteria 990503
 Terrazzo design
Terrazzo design
 Terrazzo 990701
Terrazzo 990701
 Terrazzo 990702
Terrazzo 990702
 Terrazzo 990703
Terrazzo 990703
 Terrazzo 990704
Terrazzo 990704
 Terrazzo 990705
Terrazzo 990705
 Terrazzo 990706
Terrazzo 990706
 Terrazzo 990707
Terrazzo 990707
 Terrazzo 990708
Terrazzo 990708
 Terrazzo 990709
Terrazzo 990709
 Terrazzo 990710
Terrazzo 990710
 Terrazzo 990711
Terrazzo 990711
 Terrazzo 990712
Terrazzo 990712
 Terrazzo 990713
Terrazzo 990713
 Wool design
Wool design
 Wool 990601
Wool 990601
 Wool 990602
Wool 990602
 Wool 990603
Wool 990603
 Wool 990604
Wool 990604
 Wool 990605
Wool 990605
 Wool 990606
Wool 990606
 Wool 990607
Wool 990607
 Wool 990608
Wool 990608
 Wool 990609
Wool 990609
 Wool 990610
Wool 990610
 Wool 990611
Wool 990611
 Wool 990612
Wool 990612